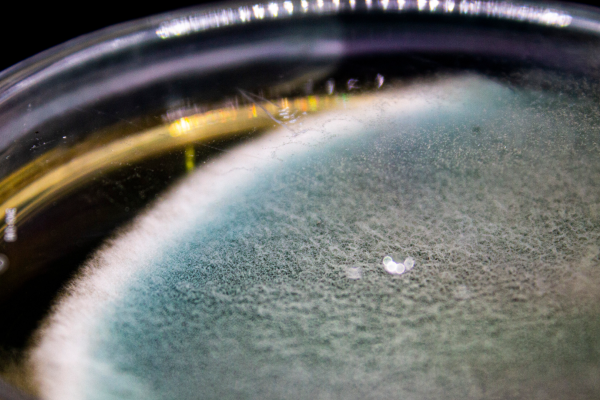

Excelência em Diagnósticos
Conheça nossas metodologias em exames clínicos
A contribuição laboratorial para o diagnóstico veterinário é imensa para qualidade de vida e manutenção da saúde animal.
A cada dia, novos exames e novas técnicas de alta sensibilidade são utilizados como recursos auxiliares para avaliação e conduta. Assim, o IntegraLab exerce seu papel com excelência, atuando como suporte e parceiro do médico veterinário e da agroindústria na solução de diversos casos que surgem na sua prática diária. Na área de saúde e sanidade animal, oferecemos serviços diversificados e atualizados, destacando-se pelo atendimento de qualidade, consultoria especializada, soluções logísticas e rapidez na entrega de resultados.